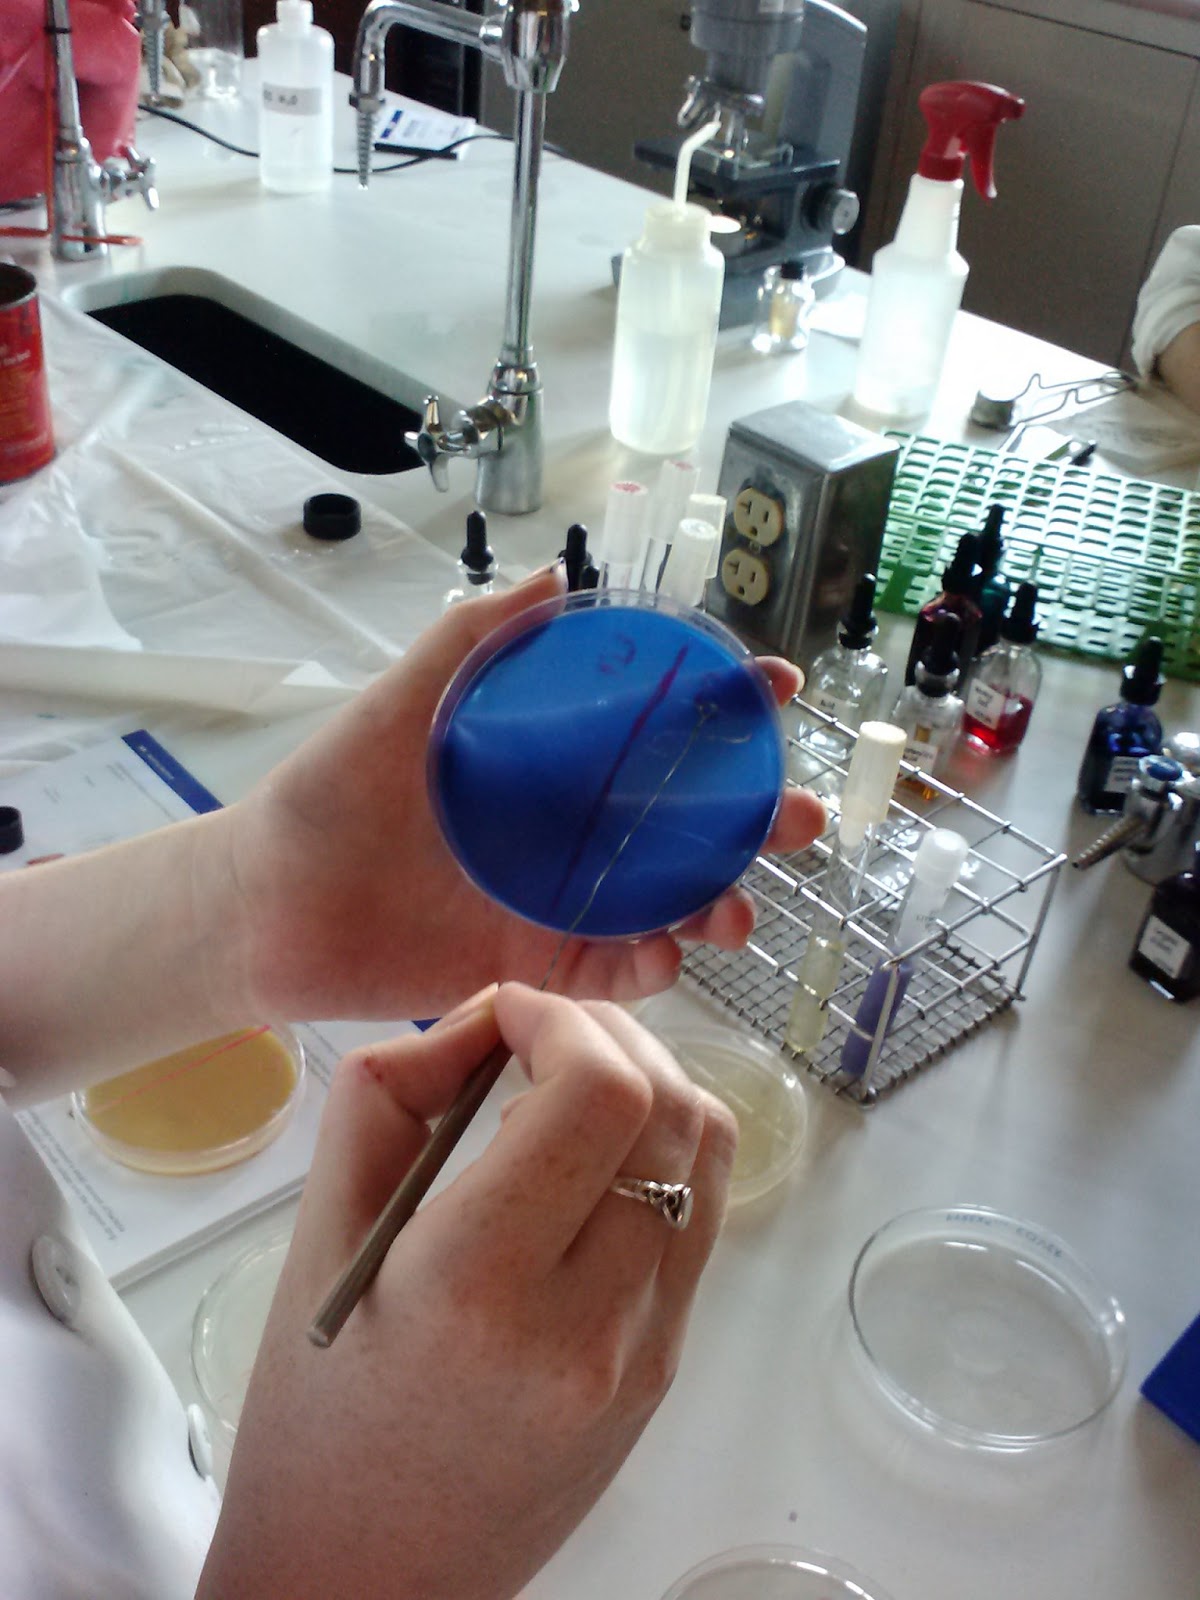

Today we continued staining bacteria!
Preparing an
Endospore stain:
To prepare an endospore stain we made
a slide with fixed smear of bacteria. We then took a beaker and put water in it
and boiled the water. We placed the slide on the beaker. We then placed paper
on the slide and saturated the paper with malachite green. We stained for 5-6
minutes after the malachite green began to steam. We added additional stain as
it evaporated making sure the stain does not dry.
We then removed the slide from the
heat and removed the paper, and allowed the slide to cool.
Then we rinsed the slide with water
for 30 seconds to remove excess malachite green. We covered the smear with
safranin for 60-90 seconds. Then we rinsed the slide with water to remove
excess safranin. Then we blotted the slide with pieces of bibulous paper and
examined the side under the microscope suing oil immersion lens.
In examining the bacteria we were
able to determine that our bacteria has no endospores.
Preparing a Capsule
stain:
We prepared a capsule stain in
order to view bacterial capsules and slime layers. We prepared a smear of
bacteria in nigrosin by doing the procedure for a negative stain. We let the
spread smear air dry and then covered it with safranin or crystal violet.
We then gently washed off the
excess stain, and blotted the slide with bibulous paper.
We then examined it under the
microscope with the oil immersion lens.
In examining the bacteria we were
able determine that our bacteria was not capsulated. With this staining we were
also able to confirm that our bacteria is rod-shaped.
Finding out what our bacteria consumes:
Finding out what our bacteria consumes:
We did motility by adding our bacteria to it in a straight
line by straight inoculation, and then placing it in the incubator.
We did Litmus milk, and added the bacteria to it by putting
a loop full of bacteria into it and then incubating it.
We did gelatin by doing straight inoculation with our
bacteria and putting a straight line of bacteria into the gelatin.
We had 3 plates: Casein, lipid and starch. On each plate we
took our bacteria into a loop and drew the bacteria onto the plate in a snake
shape, and then incubated it.

No comments:
Post a Comment